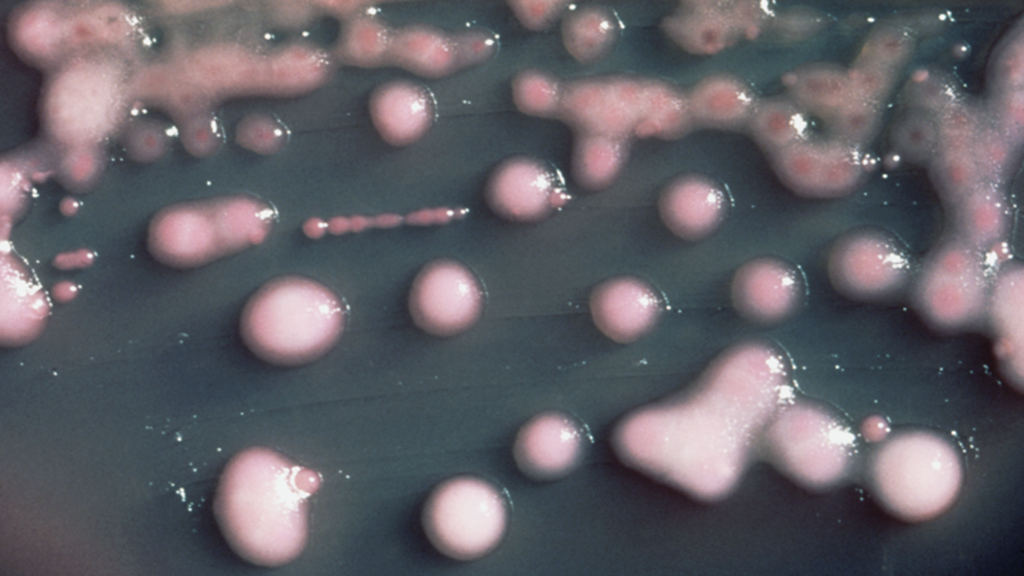
new delhi bakteria - Wikipedia

- Z bakterią zmagają się w tej chwili szpitale w województwach: mazowieckim, podlaskim i warmińsko-mazurskie. Stamtąd New Delhi może trafić do naszego regionu - mówi dr Tomasz Ozorowski.
- W poznańskich szpitalach problem New Delhi udało się rozwiązać w 2015 dzięki skoordynowanym działaniom Wojewódzkiej Stacji Sanepidu we współpracy ze szpitalami. Natomiast z powodu tego, co dzieje się na terenie innych województw - przede wszystkim Mazowsza - jesteśmy w stałym pogotowiu i czujemy zagrożenie, które może wrócić wraz z przekazywaniem pacjentów z Mazowsza. Mamy już doświadczenia, w jaki sposób rozwiązywać problem New Delhi, ale jest to problem, który wymaga trzymania ręki na pulsie – tłumaczy.
W Poznaniu rozpoczęło się w środę Forum Szpitali Klinicznych. Kilkudziesięciu dyrektorów placówek uniwersyteckich rozmawia między innymi o zakażeniach szpitalnych.
W wielkopolskich szpitalach w przypadku podejrzenia zakażenia New Delhi pacjenci od razu przechodzą specjalistyczne badania, by szybko wykryć bakterię i od razu izolować pacjenta.











